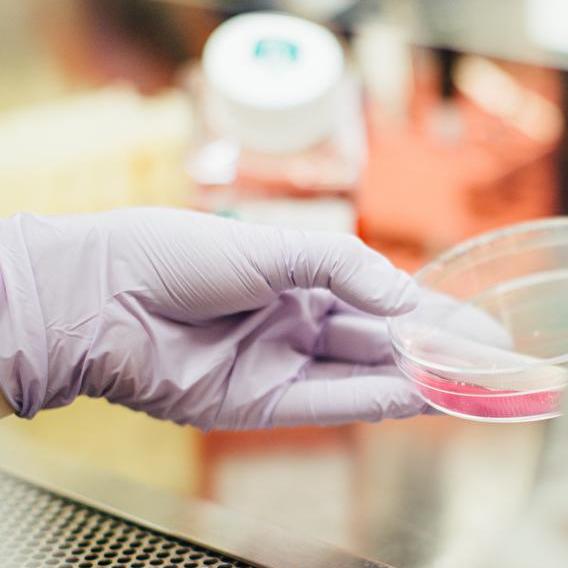

RW- 660ème Conférence internationale sur le génie chimique et biochimique (ICCBE)
Research World Suivre
La RW6060e Conférence internationale sur le génie chimique et biochimique (ICCBE) est un événement prestigieux organisé avec la motivation de fournir une excellente plate-forme internationale aux universitaires, chercheurs, ingénieurs, industriels et étudiants en herbe du monde entier pour PARTAGER leurs résultats de recherche experts mondiaux. La 660ème édition de l'ICCBE 2019 se tiendra à Luxembourg (Luxembourg) du 23 au 24 août 2019.
L'intention principale de la 660ème ICCBE 2019 est de donner aux participants du monde entier la possibilité de partager leurs idées et leurs expériences en personne avec leurs pairs qui devraient rejoindre des parties différentes du monde. En outre, ce rassemblement aidera les délégués à établir des relations de recherche ou d’affaires, ainsi qu’à établir des liens internationaux pour de futures collaborations dans leur cheminement de carrière. Nous espérons que les résultats du 660e ICCBE 2019 apporteront des contributions significatives à la base de connaissances dans ces domaines scientifiques actualisés.
Organisateur
Research World
Où ça se passe ?
NH Hôtels
1 Route de Trèves
2633 Senningerberg
Luxembourg
Luxembourg
Tu pourrais aussi aimer :

retrouve tous les networkings et formations qui te ressemblent !
retrouve tous les networkings et formations qui te ressemblent !